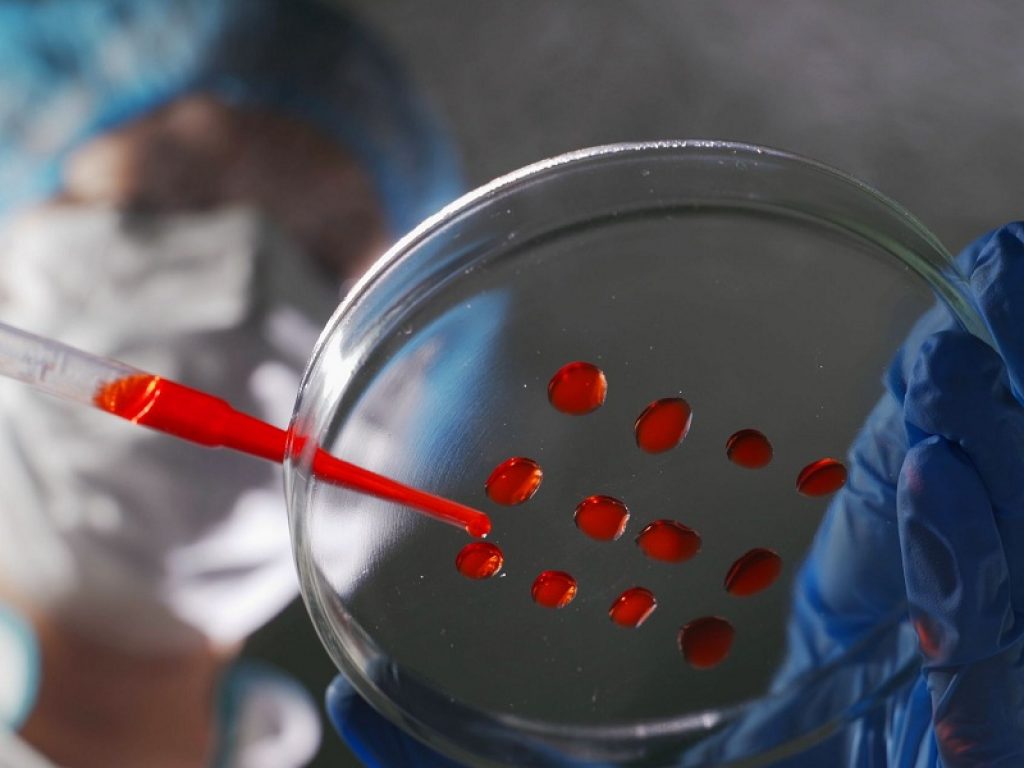

Secondo un nuovo studio, un set di 15 biomarcatori ematici sarebbe in grado di battere i metodi convenzionali per la predizione della gonartrosi
I risultati di uno studio pubblicato su Science Advances hanno identificato un set di 15 biomarcatori ematici che sarebbe in grado di battere i metodi convenzionali per la predizione della gonartrosi.
Gli autori dello studio hanno sottolineato la rilevanza dei risultati preliminari ottenuti in quanto l’analisi dei biomarcatori ematici è di facile esecuzione e potrebbe, in prospettiva, facilitare l’identificazione dei soggetti da reclutare nei trial clinici sull’artrosi (OA) e quelli maggiormente necessitanti di trattamento.
Razionale e obiettivi dello studio
I pazienti affetti da OA presentano, notoriamente, variazioni notevoli dei tassi di progressione della malattia: quando mostrano i primi segni di danno articolare, alcuni peggiorano fino a richiedere una sostituzione del ginocchio in pochi anni, mentre altri non raggiungono mai quel punto.
Questo aspetto è particolarmente importante quando si progettano gli studi su potenziali terapie farmacologiche o di altro tipo, dato che la selezione di pazienti che hanno una progressione rapida di malattia potrebbe ridurre sia il numero di pazienti che la durata del follow-up necessario per determinare se un trattamento funziona.
Attualmente, il trattamento per l’OA è solo sintomatico e non in grado di intervenire per cambiare la storia di malattia. Ciò è dovuto principalmente alla presenza di due ostacoli principali: 1) l’incapacità di individuare l’OA in modo sufficientemente precoce, prima dell’insorgenza di segni irreversibili; 2) l’incapacità di identificare in modo affidabile gli individui a rischio elevato di progressione di OA, con conseguente tasso elevato di errori di tipo II, cioè di studi sull’OA con falsi negativi, dovuti all’impossibilità di osservare l’effetto del trattamento su un end point strutturale dell’OA, come una radiografia del ginocchio, che può solo peggiorare ma non migliorare in una coorte la cui OA strutturale è relativamente stabile.
Le misure tradizionalmente utilizzate per prevedere la progressione dell’OA, come l’età, il sesso, l’indice di massa corporea (BMI) e la gravità radiografica dell’OA, sono minimamente prognostiche di peggioramento strutturale di malattia.
L’obiettivo dei ricercatori è stato quello di identificare l’esistenza di biomarcatori nel sangue, facilmente rilevabili, in grado di predire una progressione clinicamente rilevante della gonartrosi – definita dalla combinazione di deterioramento della struttura articolare e di peggioramento del sintomo “dolore” a 48 mesi.
Lo studio in breve
I ricercatori hanno preso in considerazione per il loro studio una coorte di 596 pazienti affetti da OA del ginocchio, messa a punto all’inizio dello scorso decennio, sottoposta a prelievo ematico al reclutamento.
Questi sono stati sottoposti ad un follow-up di 48 mesi, che prevedeva la misurazione radiografica dell’ampiezza dello spazio articolare e del dolore auto-riferito.
Al basale, i partecipanti allo studio avevano una OA di grado 1-3 in base alla scala Kellgren-Lawrence (12% di grado 1, 51% di grado 2 e 37% di grado 3), con punteggi medi WOMAC relativi al dolore percepito pari a 12.
Alla fine del follow-up:
– un terzo dei membri della coorte non aveva riferito dolore o mostrato progressione radiografica di malattia;
– un altro terzo di pazienti, invece, era andato incontro a progressione sia del danno radiografico che del dolore percepito;
– circa 100 pazienti, invece, erano andati incontro a progressione radiografica di malattia o del dolore percepito
A questo punto, i ricercatori hanno misurato dal sangue prelevato più di 100 peptidi derivati da 64 proteine nei campioni di sangue. Un’ulteriore analisi ha permesso di restringere il campo a 15 marcatori, corrispondenti a 13 proteine totali, che sono risultate le più adatte a predire una rapida progressione di malattia.
Tre proteine sono apparse particolarmente importanti per la prognosi. Una di queste è la proteina legante la vitamina D che, stando a studi precedenti “avrebbe una moltitudine di funzioni”
“Curiosamente – hanno notato i ricercatori – questa proteina non sembra essere espressa all’interno dell’articolazione, ma “riflette comunque l’esistenza di processi rilevanti per la patologia dell’OA”.
Le altre due proteine, CRAC1 e C1R, sono prodotte nel tessuto sinoviale e “potrebbero essere considerate biomarcatori ‘diretti’ … associati alla patogenesi della malattia”, hanno aggiunto i ricercatori.
L’analisi della curva ROC di questo set di biomarcatori ha mostrato un’accuratezza del 73% nel distinguere i pazienti con peggioramento sostanziale della loro artrosi durante 4 anni di follow-up clinico rispetto ad un’accuratezza del 59% ottenuta i base ad un modello standard di predizione della progressione di malattia basato su dati radiografici e la severità del dolore al reclutamento di questi pazienti nello studio.
Non solo: l’accuratezza predittiva del set di biomarcatori è stata superiore anche al singolo biomarcatore attualmente in uso che misura i livelli urinari della porzione carbossi-terminale del telopeptide cross-linkato del collagene di tipo 2 (uCTXII), che si attesta intorno al 58%.
La predittività di questo set di biomarcatori è stata valutata, successivamente, in un’altra coorte separato di 86 pazienti con gonartrosi, seguiti clinicamente per 3-4 per evidenziare la progressione radiografica di malattia.
Di questi 86 pazienti, 49 non sono andati incontro a peggioramento del danno radiografico, a differenza dei rimanenti 37.
In questo gruppo, il set di 15 biomarcatori ematici ha avuto un’accuratezza del 70%, in base alla curva ROC, nel predire il peggioramento radiografico di malattia.
Riassumendo
In conclusione, i risultati di questo studio hanno verificato che il ricorso ad una combinazione di biomarcatori ematici è un grado di migliorare notevolmente l’accuratezza nel predire la progressione di OA del ginocchio rispetto alle metodologie esistenti, poco affidabili nella prognosi e diagnosi di questa malattia, come pure rispetto all’unico biomarcatore attualmente in suo, uCTXII.
L’impiego di questo set sembra molto promettente sia ai fini dell’ottimizzazione dei trial clinici che della personalizzazione futura dei trattamenti, quando saranno disponibili i primi DMOAD in grado di cambiare il decorso di questa malattia.
Bibliografia
Zhou K, et al “A ‘best-in-class’ systemic biomarker predictor of clinically relevant knee osteoarthritis structural and pain progression” Sci Advances 2023; DOI: 10.1126/sciadv.abq5095.
Leggi